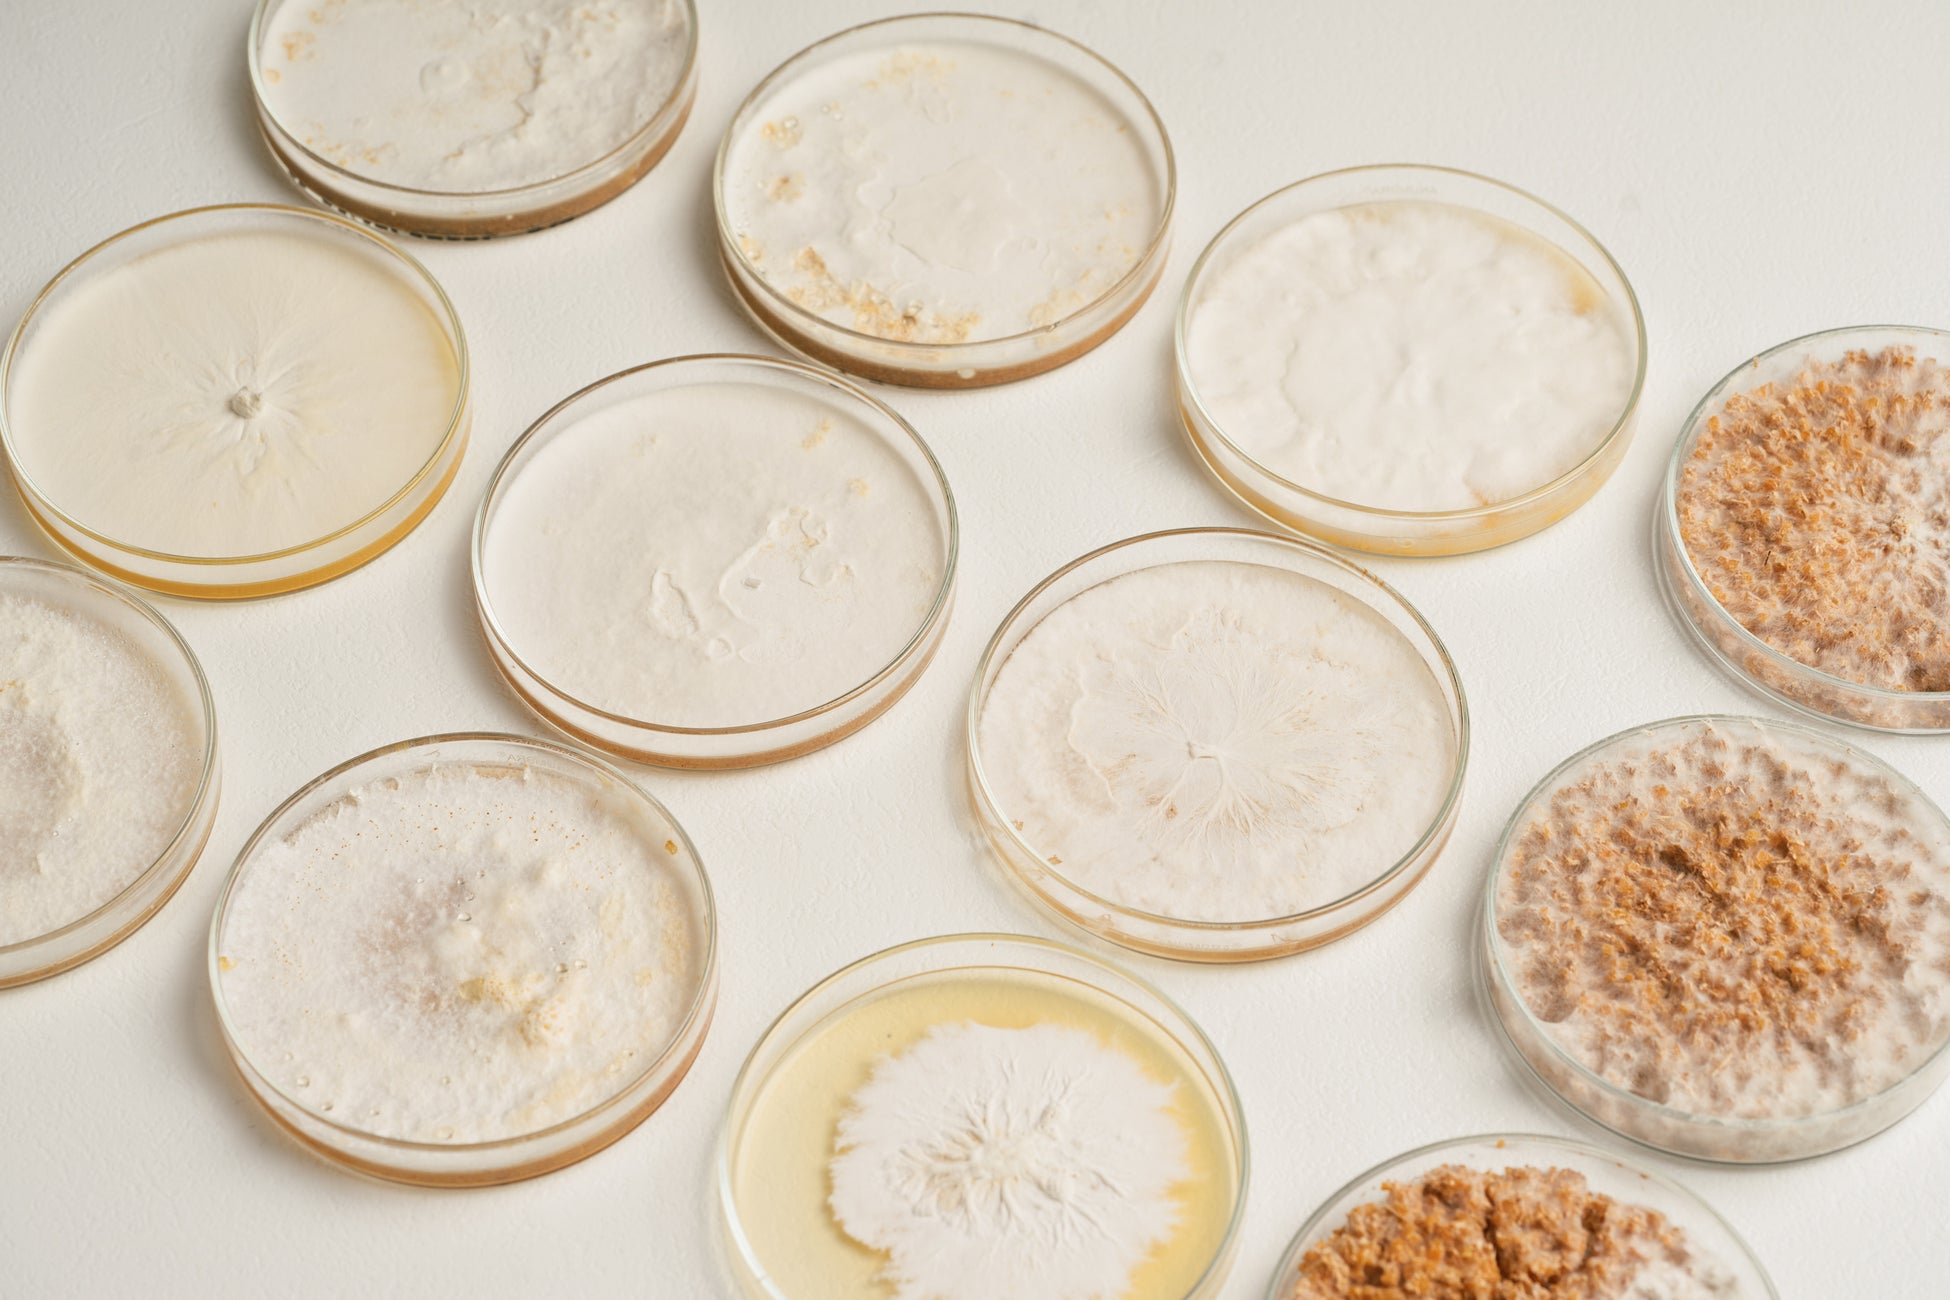

【信州発】もう「本革か合皮か」で悩まない。サステナブルな第3の選択肢、菌糸素材のApple Watchベルトが誕生!Makuakeで先行販売。
この革新的な素材の持つ独特の質感、心地よさ、そして未来への可能性を、まずはあなたの肌で直接感じてほしい。

MYCL Japan株式会社(本社:長野県小諸市、代表取締役:乾馨太)は、キノコの菌糸体から生まれた100%自然素材「キノコの皮KINOLI®」を使用したApple Watch専用ベルトの先行販売を、2025年6月25日10時より応援購入サービス「Makuake」にて開始いたしました。
■ 背景・課題
近年、環境への配慮から動物性素材や石油由来素材に代わるサステナブル素材の需要が高まっています。 しかし、Apple Watchベルトの多くは動物性素材や石油由来の合成皮革であり、環境性能と心地よい肌触りを両立した選択肢は限られていました。また、新素材はまず手に取ってその良さを体感していただく機会の創出が課題となっていました。

■ 製品概要
今回Makuakeで発表する製品は、キノコの菌糸体100%で作られた「キノコの皮KINOLI®」を表皮に使用したApple Watch専用ベルトです。 菌糸がもたらす、しっとりとして吸い付くような優しい肌触りが最大の特徴で、従来の革製品にはない独特の質感とサステナビリティを兼ね備えています。 また、毎日使うものだからこそ、丈夫な異素材ハイブリッド構造を採用し、長く使える耐久性も実現しました。




「KINOLI Apple Watchベルト」の特徴
驚きのしなやかさと本革のような質感
手に取れば、まずその軽さに驚くはずです。そして、しなやかに曲がる柔軟性は、菌糸ならではの微細な構造が生み出す独自の特性です。
異素材の融合が生む、快適さと信頼感
表面には軽くてしなやかなKINOLIを、そして肌に触れる裏面と、ベルトとしての強度が必要な部分には、上質で丈夫な国産「姫路レザー(牛革)」を採用しました。このハイブリッド構造により、新素材の心地よさと毎日使う道具としての実用性を両立させています。
細部に宿る、信州のモノづくり
ベルトの縁を彩る「コバ」の仕上げ、均一で美しい「ステッチ」、そして確かな品質の金具。一つひとつのディテールにも、信州・小諸を拠点とする私たちのモノづくりへのこだわりが息づいています
製造国は日本です 。

■ 小諸市長からのメッセージ
「KINOLIは環境へのやさしさと美しさ、使い心地を両立した画期的な素材です 。菌糸とは思えないその質感と背景にある技術力は、多くの人の心に届くはず 。地元自治体として、未来を担う素材としてのさらなる展開に大いに期待しています 」。
■ 仕様
対応サイズ
Sサイズ: 38mm, 40mm, 41mm, 42mm
Lサイズ: 42mm, 44mm, 45mm, 46mm, 49mm
ベルト長
Sサイズ: 約130mm ~ 約160mm
Lサイズ: 約150mm ~ 約190mm
素材表地: KINOLI(菌糸)
裏地: 姫路レザー(牛)
カラー: ナチュラル、オリーブ
製造国: 日本
■ Makuakeプロジェクトの詳細
プロジェクト名: 【信州発】触れるたび心地良い。未来の菌糸素材Apple Watchベルト、誕生!
期間: 2025年6月25日 ~ 2025年8月29日
URL: https://www.makuake.com/project/kinoli_watch/
応援購入割引(全て送料無料 ):
【超早割】20%OFF
【早割】15%OFF
【マクアケ割】10%OFF
【かけこみ割】5%OFF
【セット割】17%OFF
■ 会社概要
社名:MYCL Japan株式会社
所在地:長野県小諸市本町1-2-13
代表者:代表取締役 乾馨太
設立:2022年7月
事業内容:キノコ菌糸を活用した新素材の研究開発・製造・販売
このプレスリリースには、メディア関係者向けの情報があります
メディアユーザー登録を行うと、企業担当者の連絡先や、イベント・記者会見の情報など様々な特記情報を閲覧できます。※内容はプレスリリースにより異なります。
すべての画像